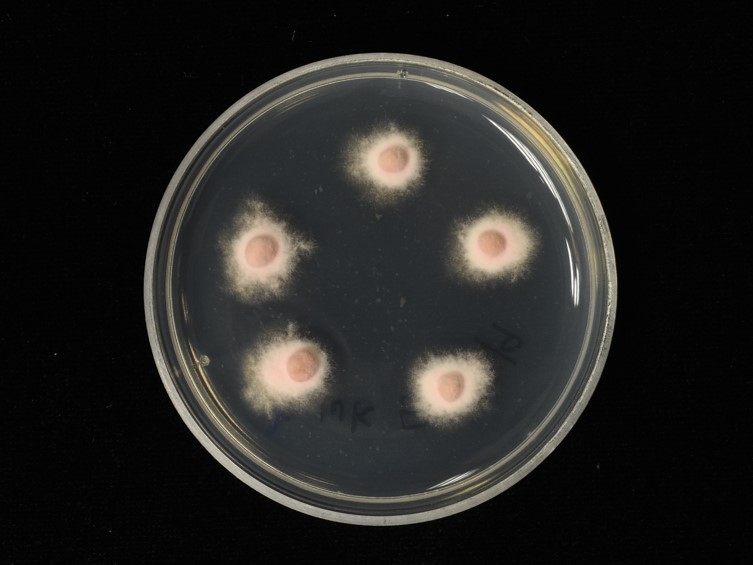

Holotype:
THAILAND, Phitsanulok Province, Ban Phaothai Community Forest, 3 Sep. 2016, K. Tasanathai, S. Mongkolsamrit, D. Thanakitpipattana, W. Noisripoom, R. Somnuk, P. Srikitikulchai, S. Wongkanoun, holotype BBH 42268, ex-type living culture BCC 84234.
Habitat:
Leaf litters.
Host:
Adult of stink bug.
Description:
 Stromata solitary or multiple, arising from thorax of adult stink bug, 30-130 mm in length, 1-2 mm in breadth, black or blackish brown, curved, becoming light yellowish pink or moderate reddish orange below the fertile head. Fertile head cylindrical, 5-20 mm long, 2-3 mm broad, strong reddish orange or light yellowish pink when fresh, moderate orange yellow to brownish orange when dry.
Stromata solitary or multiple, arising from thorax of adult stink bug, 30-130 mm in length, 1-2 mm in breadth, black or blackish brown, curved, becoming light yellowish pink or moderate reddish orange below the fertile head. Fertile head cylindrical, 5-20 mm long, 2-3 mm broad, strong reddish orange or light yellowish pink when fresh, moderate orange yellow to brownish orange when dry.  Perithecia completely immersed, narrow obpyriform with a long curved neck, oblique in arrangement, 750−1200 × 200−300 μm.
Perithecia completely immersed, narrow obpyriform with a long curved neck, oblique in arrangement, 750−1200 × 200−300 μm.  Asci cylindrical, 200-600 × 5-6 μm, with cap 6-8 μm thick.
Asci cylindrical, 200-600 × 5-6 μm, with cap 6-8 μm thick.  Ascospores hyaline, multiseptate, breaking into 64 part-spores, cylindrical or slightly barrel-shaped, 6−14 × 1.5-2 μm. Anamorph: Hymenostilbe. Phialides produced on the terminal end of stromata, strong reddish orange. The anamorph develops at the end of the stroma first, followed by the development of the teleomorph at the same location at the end of the stroma as the fungus matures. Phialides cylindrical to ellipsoidal with papillate end, 10-22 × 4-6 μm. Conidia smooth-walled, hyaline, single-celled, fusoid, 4-5 × 2-3 μm.
Ascospores hyaline, multiseptate, breaking into 64 part-spores, cylindrical or slightly barrel-shaped, 6−14 × 1.5-2 μm. Anamorph: Hymenostilbe. Phialides produced on the terminal end of stromata, strong reddish orange. The anamorph develops at the end of the stroma first, followed by the development of the teleomorph at the same location at the end of the stroma as the fungus matures. Phialides cylindrical to ellipsoidal with papillate end, 10-22 × 4-6 μm. Conidia smooth-walled, hyaline, single-celled, fusoid, 4-5 × 2-3 μm.
Culture characteristics:
Colonies on PDA growing with a diam of 8–10 mm in 35 d, pale purplish pink to moderate purplish pink, reverse pale brown.
Colonies on PDA growing with a diam of 8–10 mm in 35 d, pale purplish pink to moderate purplish pink, reverse pale brown.  Conidia and reproductive structures were not produced on PDA.
Conidia and reproductive structures were not produced on PDA.
Reference:
Khao-ngam S, Mongkolsamrit S, Rungjindamai N, et al. (2021). Ophiocordyceps asiana and Ophiocordyceps tessaratomidarum (Ophiocordycipitaceae, Hypocreales), two new species on stink bugs from Thailand. Mycological Progress 20: 341–353.
DOI: https://doi.org/10.1007/s11557-021-01684-x008Species |
Strain |
Compound |
Pubchem CID |
Biological activity |
Reference |
|---|
|
Strain |
|---|